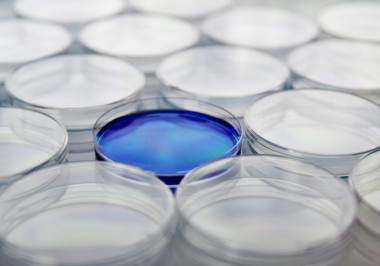

Service-Segmente
Unsere Expertise erstreckt sich im Wesentlichen auf fünf Felder:
Life Sciences
Der Geschäftsbereich Life Sciences forscht an Arzneimitteln, Medizinprodukten und Diagnostik im Gesundheitswesen. Das CERTANIA Netzwerk erfüllt dabei hohe wissenschaftliche Standards und internationale Anforderungen.
Food & Consumer Goods
Wir sichern die Sicherheit und Qualität von Lebensmitteln und Konsumgütern durch unabhängige Prüf-, Inspektions- und Zertifizierungsdienstleistungen. Unsere Experten führen mikrobiologische und chemische Analysen sowie Inspektionen nach GAP-Richtlinien durch.
Industrials
Von der Materialprüfung bis zur Zertifizierung erneuerbarer Energien bieten wir umfassende Prüf-, Inspektions- und Zertifizierungsdienstleistungen. So unterstützen wir Unternehmen in den Bereichen Automotive, Industrie und Energie dabei, höchste Leistungs- und Qualitätsstandards zuverlässig zu erreichen.
Buildings & Infrastructure
Wir bieten umfassende Inspektions-, Prüf- und Analysedienstleistungen für Gebäude, Infrastruktur und Umwelt – und gewährleisten dabei Sicherheit, Qualität und die Einhaltung von Standards in den Bereichen Materialien, Luft, Boden und Sportanlagen.
Certification & Compliance
Unsere spezialisierten Dienstleistungen stellen sicher, dass Ihre Produkte und Dienstleistungen höchsten Standards entsprechen. Wir bieten umfassende Auditierung, Zertifizierung und Beratung, um die Einhaltung von Vorschriften in den Bereichen Nachhaltigkeit, Qualität und ESG zu gewährleisten.